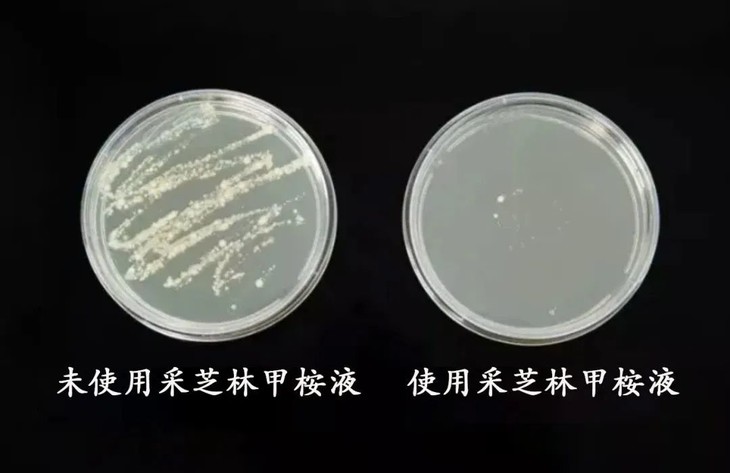

俗语说“得了灰指甲,一个传染俩!”
这句话真不是一点都不夸张!
灰甲的传染性也非常强,近距离接触、共用洗脚盆、指甲剪等,一不小心就会连累家人受罪,小宝宝也不能幸免。

得了灰指甲,指甲会变色、增厚、蛀空,甚至甲床脱离...
平时连伸出手和别人握手都不好意思!

要知道手是人的第二张脸,无论男女,拥有一双精致的手,不仅会给人际交往带来便利,也能从侧面看出一个人的生活状态。

流行病学数据显示:2%~18% 的人患有灰指甲。
灰指甲会引起指甲变色、变厚、变碎或畸形,影响美观。

而之所以会得灰指甲,是因为真菌感染了指甲盖或指甲盖下的皮肤,导致甲板凹凸不平、长有白斑、变厚浑浊......

每年春夏,随着气温的升高,脚部排汗量也会加大。
鞋袜内出现真菌喜欢的高温潮湿环境,真菌就会大量滋生,灰指甲就会进入到一个感染的高发期!

灰指甲属于那种「伤害性不大,烦恼度极高」的疾病。
不痛不痒,但是真的很丑,每当需要露指(趾)甲的时候,真想原地隐藏起来。
很多人为了去除灰指甲,不惜花费大价钱,可花钱多还不一定能看好!

要命的是,就算「忍痛拔甲」,也还是不一定能根zhi.....

小编前两年就染上了灰指甲,一开始大拇指微微发黄,后来越来越严重,指甲变厚、萎缩,表面凹凸不平,而且传染给了其他手指和脚趾甲!

去年端午假期回家,饭桌上我妈一直盯着我的手指甲:
你这个指甲实在是有点难看,年纪轻轻地长灰甲显得人好邋遢......
我妈这么一说,虽然没有外人,但是也加重了我的心理负担......
说来大家可能不信,小编之前对于灰甲总是介于「真的不好看去治吧」跟「小毛病懒得治」之间的纠结。
直到去年我妈说的这句话,让我下定决心要看好灰甲!
过程中也踩了不少坑,拔甲、包甲、泡醋、敷蒜都试过,灰甲还是没好.....

后来我才知道灰甲属于真菌感染,所以能抑菌的外用药才是能解决灰甲的方法。
对比了十几家灰甲外用药的成分,我才选中了这款主打抑菌效果的采芝林甲桉液

每天早晚各涂一次,坚持一段时间后,坏甲就自动脱落了!
那段时间工作忙,经常会忘记涂,断断续续的用了快三个月指甲才恢复健康!
虽然恢复的慢,但是确实很有效,停用后到现在也没有复发,真的很惊喜!

如果有朋友跟小编一样,被灰甲困扰,一定要用用这款采芝林甲桉液
不管是陈年已久的发硬灰指甲,还是新gan染的各种指甲问题,都可以用它!


这款真的是小编淘汰了十几家款灰甲液选中的!
采芝林是有两百多年历史的老字号了,品质大家完全可以放心!
这款甲桉液使用天然草yao配方,对皮肤没有刺激,冷萃蒸馏工艺,保留7种草本精粹,使用起来非常安心。

还特别添加了水杨酸成分,能够让坚硬灰甲变得松软,滋养甲周皮肤,帮助指甲恢复柔韧光泽。
只要在指甲上滴一滴,软化角质、舒缓灭炎、滋养甲床,坚持使用一段时间后,老指甲脱落,继而长出圆润光泽的健康新甲。


同时,苯甲酸、枯矾和滑石粉都有很好的抑菌杀菌效果,能有效抵御菌群,改善甲周的菌群环境,在使用后24小时内抵御菌群的效果均在99%以上。
再加上能够促进药物渗透吸收的乙醇,确保药物定向指甲内部渗透,直至甲床,从根源抑菌,恢复指甲健康!

滴灌设计,轻轻一滴涂抹到甲面,方便不浪费。

平时甲周皮肤容易干燥、长倒刺,也可以涂它保湿润养,让指甲清透~
因为效果出众,采芝林甲桉液一上市就受到各大药房推荐,消费者青睐。
据统计,目前已经帮助数万人解决脚部问题。
全网好评就是实力的证明!!!


广药白云山是我国知名的制药企业,也是yi疗健康产业的龙头企业。


「采芝林」就是广药旗下现存的“百年中药名企”之一!
创立于清乾隆五十六年(1791年)是中国知名的药企连锁企业,实力可见一斑。

拥有强大的专家研发团队和核心技术,10W级无菌生产车间,因此这款甲桉液,背景真的很硬。

采芝林传统中药文化已被列入广东省非物质文化遗产名录,这是几百年的积淀才有的殊荣。

靠谱的品牌很重要!
这也是为什么小编的灰甲恢复了!为什么给大家推荐这款灰甲液的原因!



很多人不知道为什么会得灰甲,其实本质是因为指甲/趾甲的真菌感染。
而灰指甲之所以麻烦难治,原因就在于真菌没有断根,反复出现。
所以对付灰甲的第一步就是:灭菌、抑菌!

但是引起灰甲的病原真菌,对一般剂物的敏感性非常差,很多仅添加化学杀菌剂的产品,使用效果都不尽人意。
采芝林团队前后花了多年时间终于攻克了这一难关,甄选艾叶、土茯苓、白鲜皮、金银花、蒲公英、益母草、土槿皮7种中草yao成分。

并把它们精细微化成小分子,作用力、渗透性都比市面上普通抑菌液要高!

不仅如此,甲桉液还加入了灰甲克星——苯甲酸!
它具有软化角质、消毒防腐和杀菌的作用,能够有效的抑制真菌!

研发团队还专门做了一组实验↓↓↓
「采集了一些真菌样本进行培养,用甲桉液进行对照」
结果,一边是细菌痕迹明显,而甲桉液所在的培养皿几乎没有菌落!
实验过程将近24小时,说明采芝林甲桉液是可以长时间保护指甲的!
这就是对付灰指甲的第二步:形成生物膜。
涂抹甲桉液后,有效成分会在甲面形成一道保护膜。

让指甲在生长过程中始终处于无菌的状态,减少真菌的二次感染,断了灰甲反复的可能~

这样就完了吗?
第三步才是快速养出漂亮美甲的关键!
否则,手上的灰甲需要5个月以上,才能恢复,脚趾甲甚至超过9个月。

人的指甲成分,主要是由角质蛋白,而采芝林研发团队在配方里加入了修护养甲的草本精粹,能让指甲生长的更快。

再用水杨酸成分滋养甲周皮肤,帮助指甲恢复柔韧光泽!

平时爱涂指甲油和做美甲的女性,里面的化学物质会伤害角蛋白,患灰指甲的概率会高出很多。
甲桉液不仅能抑制灰甲细菌,还具有滋养美甲功效,一涂指甲会更鲜亮。


漂亮指甲又回来了~
看看用过的人真实反馈!


得了灰甲,皮肤患处相对健康肌肤会很脆弱,尤其是甲床。
所以坚决抵制大量化学添加的灰甲液!

而采芝林甲桉液,配方包含多种植物提取物和抑菌成分,含量经过科学实验配比,对皮肤没有刺激性,不伤肤。

小编还进行了PH测试,数值为5-6弱酸性,接近人体的酸碱环境,直接涂在指甲缝里也很安心。

用起来就跟涂指甲油一样,很快就干透了。
真正做到不包扎,不修甲,不痛地修复灰甲。

再也不用担心伸出手和光脚的尴尬了!
小编已经开始期待今年夏天穿凉鞋啦~

但是切记大家要坚持使用!
千万不要急功近利,因为灰甲比一般的皮肤问题都难恢复,更容易反复发作,坚持很重要。

记住用法——
1、用指甲工具先把变色变质的坏甲、死灰甲去除干净,用温水浸泡病甲10分钟,用毛巾擦干,有利于yao水更好吸收;
2、用吸管吸出甲桉液,放在甲面上,挤出少量液体即可;
3、睡前涂抹,每次涂3遍,两分钟涂1遍,也可以根据需要增加使用频率;每周把长出来的坏指甲剪掉(很重要);
4、根据自身情况在继续涂抹巩固,直至新甲长出。

每瓶包装上都有防伪码可查,大家可以放心入手!
我跟品牌方磨了好久,要来了给粉丝的专属福利!
旗舰店一瓶49的价格,我们平台粉丝只要39一瓶!
而且买2瓶送1瓶!
买3瓶送2瓶!
一瓶大概能用大半个月,根据小编恢复的时间来算,建议大家选择买3送2!5瓶刚刚好够一个疗程!
让自己远离灰甲困扰~~~
扫码关注“小来生活馆”公众号
即可领取5元无门槛优惠券!
除此之外,还有超值好礼!
关注公众号即可参与幸运大抽奖
最高可以获得价值3000元戴森吸尘器!
▼点击下方关注
